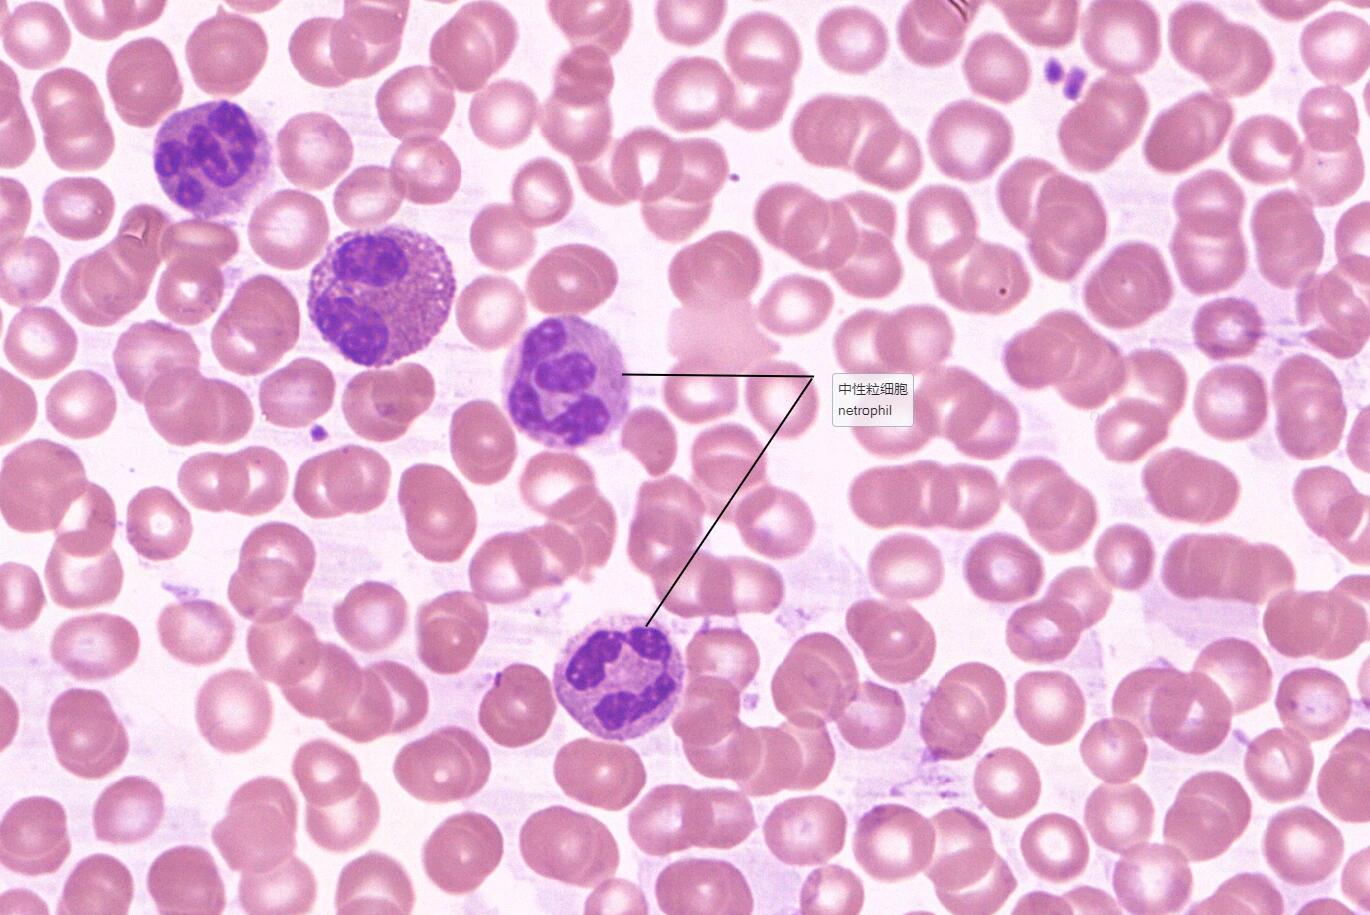
5 血液:白细胞5分类

白细胞长什么样子图片

白细胞计数:236×10的9次方每升
图片尺寸3472x4624
5 血液:白细胞5分类
图片尺寸1370x915
你身体里的免疫卫士
图片尺寸1080x1440💉白细胞:健康卫士的秘密🔍
图片尺寸1200x800
白细胞的作用到底有多大. #科普 #白细胞 #白细胞吞噬细菌
图片尺寸1080x1920白细胞类型及数量对比
图片尺寸1080x1410
白细胞计数:236×10的9次方每升
图片尺寸3472x4624白细胞医学或微生物学背景.三维演示
图片尺寸1200x800白细胞家族大揭秘:形态与功能的奇妙对应
图片尺寸1080x732
尿检—白细胞
图片尺寸1920x2560
显微镜下的白细胞全家福
图片尺寸1080x1440请你看白细胞
图片尺寸1080x1081
尿检—白细胞
图片尺寸1920x2560白细胞3.09算低吗?
图片尺寸4409x2939
身体_白细胞_科学家们
图片尺寸3000x2000
食补在提升白细胞方面确有其效吗?
图片尺寸2048x1365
白细胞计数:236×10的9次方每升
图片尺寸3472x4624
通过显微镜拍摄到的人类白细胞追逐细菌的迷人镜头
图片尺寸720x1424
白细胞正常形态绘图
图片尺寸1920x2560
你身体里的免疫卫士
图片尺寸1080x1440
猜你喜欢:正常白细胞图片大全白血球图片血小板长什么样子图片白细胞吞噬细菌白细胞的样子图片红细胞长什么样子图片白细胞真实图片白细胞长什么样图片红细胞长什么样图片白细胞工作细胞图片白细胞长什么样血小板长什么样图片白细胞图片工作细胞白细胞污图红细胞长什么样工作细胞白细胞腐图白细胞图片吞噬白细胞图片显微镜白细胞图片手绘图白细胞图片卡通癌细胞长什么样白细胞高是什么原因肉瘤是什么样子图片淋巴结是什么样子图片工作细胞白细胞女工作细胞白细胞五种白细胞形态图疣是什么样子图片青色是什么样子的图片割礼后是什么样子图片日产a平安歌手照片黑白精微素描动物镇魂符怎么画修鞋摊 肉丝金雀盆景得奖王兴权宿迁霸王举鼎简笔画奥特曼开黑华阴罗夫旅馆龙贡果苗玉带龙庭